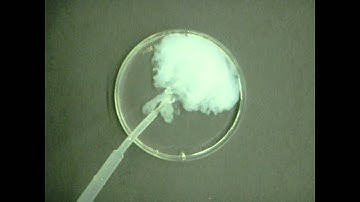
na3po4 cacl2 precipproject

⬇ DOWNLOAD NOW
Kalau muncul iklan pop-up, tutup lalu klik tombol kembali
Download lagu Na3PO4 reacting with CaCl2 demo secara gratis hanya untuk keperluan promosi. Dukung artis favorit kamu dengan membeli musik original di iTunes atau platform resmi lainnya.
 Double Displacement CaCl2 and Na3PO4
Double Displacement CaCl2 and Na3PO4
na3po4 cacl2 precipproject
na3po4 cacl2 precipproject
 Double Displacement CaCl2 and Na3PO4 YouTube
Double Displacement CaCl2 and Na3PO4 YouTube
 What type of reaction is Calcium chloride (CaCl2) and Sodium phosphate (Na3PO4)? | CaCl2+Na3PO4
What type of reaction is Calcium chloride (CaCl2) and Sodium phosphate (Na3PO4)? | CaCl2+Na3PO4
 Copper phosphate.mov
Copper phosphate.mov
 What does CaCl2 and Na3PO4 make? Na3PO4+CaCl2 | Sodium phosphate + Calcium chloride
What does CaCl2 and Na3PO4 make? Na3PO4+CaCl2 | Sodium phosphate + Calcium chloride
 19.1 - Vídeos ilustrativos - 13 - Precipitación de Ca3(PO4)2 – Displacement CaCl2 and Na3PO4 (Engl)
19.1 - Vídeos ilustrativos - 13 - Precipitación de Ca3(PO4)2 – Displacement CaCl2 and Na3PO4 (Engl)
 When aqueous sodium phosphate, Na3PO4, was added to aqueous calcium chloride, CaCl2, calcium phosph…
When aqueous sodium phosphate, Na3PO4, was added to aqueous calcium chloride, CaCl2, calcium phosph…